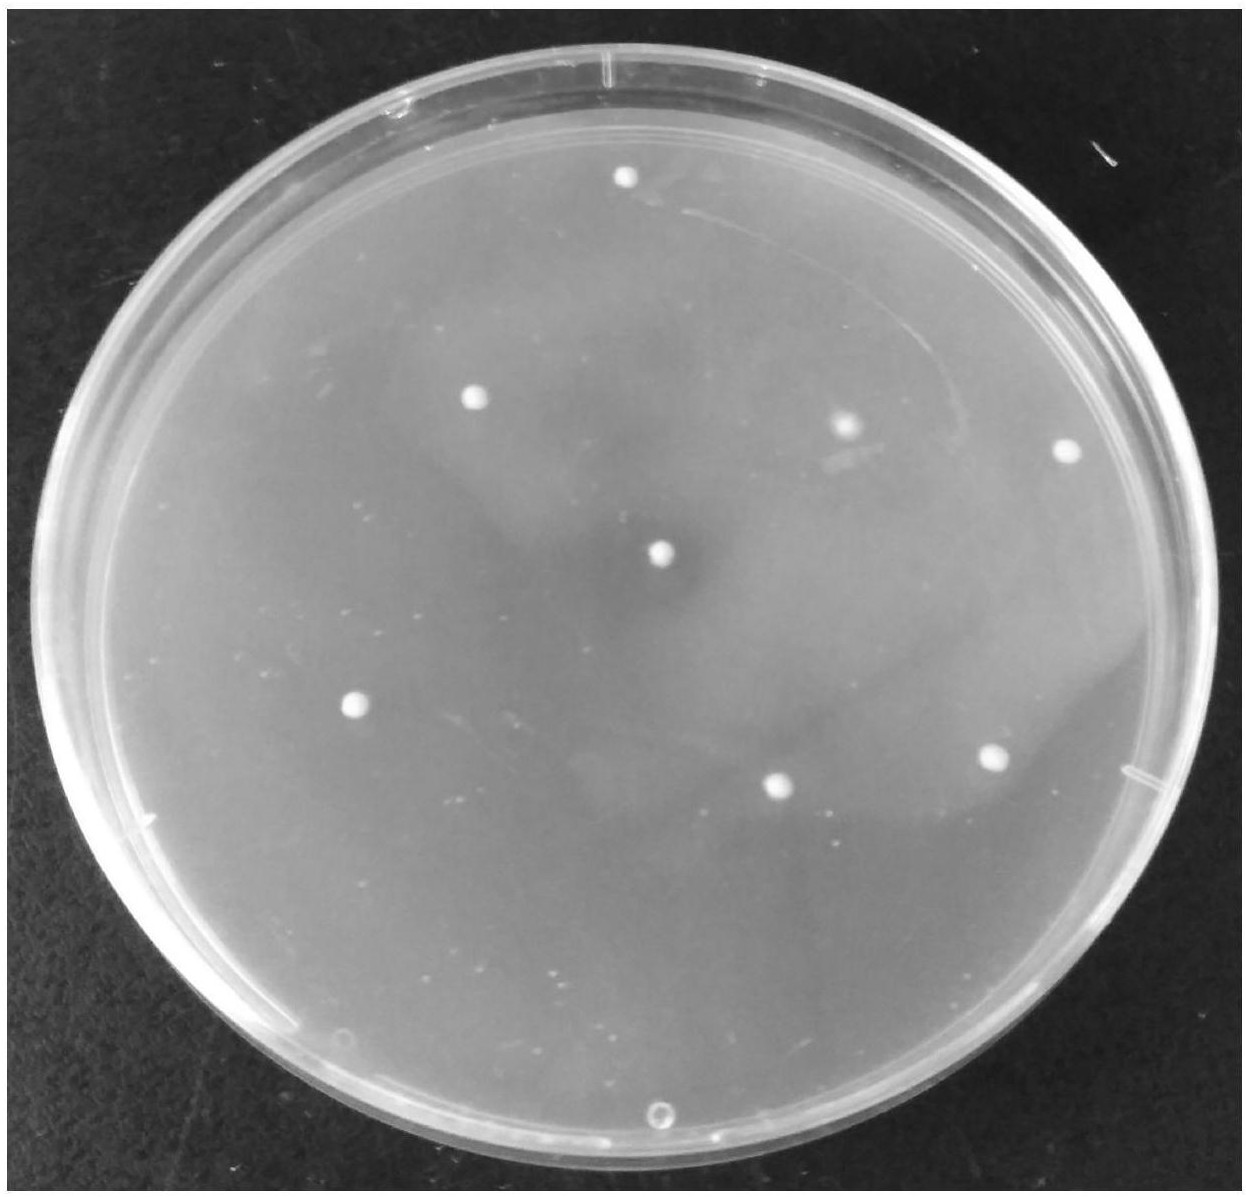
一种提高丁酸梭菌筛选效率的培养基

丁酸梭菌培养基

丁酸梭菌检验培养基 hb9191 250克/瓶 固体培养基
图片尺寸1000x1000
丁酸梭菌2
图片尺寸1200x1311
一种提高丁酸梭菌筛选效率的培养基
图片尺寸1246x1197
秦皇岛市耐酸碱商情丁酸梭菌
图片尺寸1331x1080
丁酸梭菌 - 微生物 - 培养/筛选 - 小木虫论坛-学术科研互动平台
图片尺寸612x816
一种提高丁酸梭菌筛选效率的培养基的制作方法
图片尺寸1000x960
丁酸梭菌atcc19398产乙醇乙酸强化梭菌液体培养基37度厌氧活化菌
图片尺寸800x800
丁酸梭菌培养基菌种肠道益生水产养殖对虾白便拖其他益生菌
图片尺寸800x800
丁酸梭菌水产养殖菌种培养基虾蟹塘对虾调节肠道白便空肠胃乳酸菌
图片尺寸800x800
丁酸梭菌水产养殖菌种培养基虾蟹塘对虾调节肠道白便空肠胃乳酸菌
图片尺寸800x800
丁酸梭菌培养基水产养殖牧海人丁酸菌种肠道益生菌对虾用白便拖便
图片尺寸800x800
丁酸梭菌团体标准正式发布高品质产品助力无抗养殖创新发展
图片尺寸650x650
上海邦景革兰氏染色液试剂盒打折优惠中
图片尺寸500x375
一种提高丁酸梭菌筛选效率的培养基的制作方法
图片尺寸983x1000
丁酸梭菌高清无码图来自金百合生物
图片尺寸1440x1080
丁酸梭菌培养基水产养殖牧海人丁酸菌种肠道益生菌对虾用白便拖便
图片尺寸800x800
犬真菌性皮肤病的诊治
图片尺寸404x440
根源生物枯草地衣芽孢杆菌丁酸梭菌粪肠球菌猪牛羊水产兽用益生菌
图片尺寸300x300
液体丁酸梭菌
图片尺寸750x750
强化梭菌培养基(rcm) 250g hb0316 青岛海博 现货包邮
图片尺寸800x800